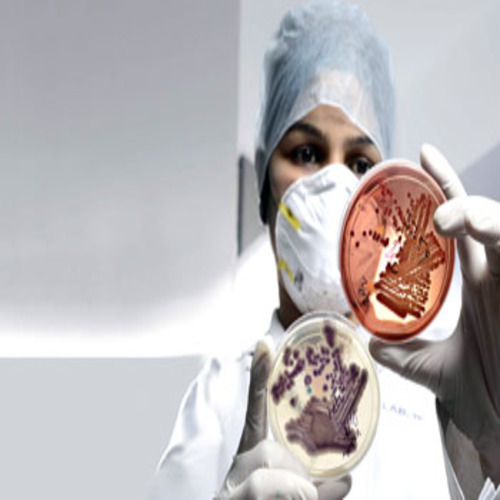
цивилизация

Едно откритие съдържащо древна нанотехнология доказва съществуването на напреднала цивилизация преди потопа Има особени открития на нашата планета Земя, които не биха могли да бъдат обяснени чрез конвенционалните методи на мислене и общоприетата история, но има необяснени много находки, които остават загадка за учените. Отрити са артефакти, които ”не са на място“, които се считат за нищо повече, освен за …
Прочети повече »Всичко за цивилизация
Открити огромни праисторически подземни структури пренаписват историята
Огромни праисторически подземни структури са открити в Турция, Израел и на други места из Средиземноморието на дълбочина няколкостотин метра Докато повечето изследователи и учени от целия свят са съгласни, че човешката цивилизация, както знаем съществува само от няколко хиляди години така както ни е позната, то има безброй открития, които сочат към много по-различно минало. Има много находки, вариращи от …
Прочети повече »Това е най-страшната заплаха за човешката цивилизация?
Лекари прогнозират настъпването на доантибиотична ера, в резултат на която световната цивилизация ще се върне към периода, когато антибиотиците все още не са били създадени В тази връзка те припомнят някои известни исторически факти, според които средната продължителност на живота в Древен Египет е била 22,5 години, в Древен Рим – 24 години, а в Средновековна Европа – 21 години. …
Прочети повече »Ето кои са петте неща, които ще се случат с човешката цивилизация!
Редица учени предвиждат, че човешката цивилизация ще преживее редица еволюционни изменения в далечното бъдеще, които ще доведат до известно физическо унифициране на расите Ето и някои от останалите възможни изменения, които може да настъпят, базирани на наблюдаваните в момента процеси на миграция, глобализация и асимилация в световен мащаб. Хората ще станат по-привлекателни на външен вид. Учените са убедени, че броят …
Прочети повече »Египет поднесе нова археологическа изненада
Египет поднесе поредната изумителна находка на света – статуя на дъщерята на фараон Аменхотеп III, съобщава за любопитното откритие сайтът actualno.com, позовавайки се на комюнике на египетското министерство на паметниците на културата Екип от египетски и европейски археолози се натъква на статуята на принцеса Исет по време на реновацията на погребалния храм на нейния баща Аменхотеп III в Луксор, Египет. Самата …
Прочети повече »Откриха 1300-годишна гробница, пълна с женски мумии
Археолози откриха голяма императорска гробница в Перу, пълна с мумии, предаде Ройтерс Откритието е направено при разкопки, а голяма част от намерените тела принадлежат на жени. Находката е от изключителна важност, защото хвърля светлина върху обвитата в загадки империя Вари, господствала над Андите много преди своите прочути наследници – инките. В изявление за медиите археолозите заявяват, че това е първата открита …
Прочети повече »Чудо! Българка пилигрим извървя магическия Ел Камино и прослави България – СНИМКИ (част 2)
Владина Цекова стана пилигрим, извървя магическия Ел Камино – пътят на Св. ап. Яков и достигна до Сантяго де Компостела Владина пътувала в компанията на Таня Ставрева – шампион по художествена гимнастика. Ел Камино може да бъде извървян за 30 дни, но двете пътешественички решили да отидат до Португалия, затова се движили малко по-бързо и в рамките на 27 дни …
Прочети повече » Чудеса.net
Чудеса.net